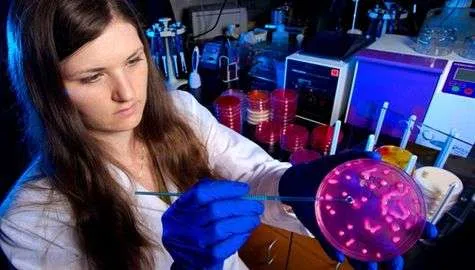

CDC microbiologist, Alicia Shams, with CRE bacteria growing on a MacConkey agar plate. Photo courtesy Centers for Disease Control.
By Kim Kalunian, WPRO News
The Centers for Disease control announced last week that they have seen an increase in incurable bacterial infections in the last decade. They are now calling on medical professionals across the country to help to stop the spread of the deadly bacteria.
According to the CDC, the bacteria, carbapenem-resistant enterobacteriaceae (CRE), kills up to half of the patients that get an infection in their blood stream. CRE bacteria can be transmitted among fellow patients in hospitals, and also among medical staff. Cases of CRE infections have been documented in 42 states, including Rhode Island.
CDC Director Tom Frieden, called CRE “nightmare bacteria” and said the “strongest antibiotics don’t work” to stop the infection.
The CRE bacteria can also transfer their antibiotic resistance to other bacteria within their family, which could create additional life-threatening infections. Almost all cases of CRE infections occur in hospitals, long-term care facilities or nursing homes.
Despite the CDC’s warning, Dr. Nicole Alexander, an adult and pediatric infectious disease physician and medical consultant for the Rhode Island Department of Health, said there’s no reason to “raise alarm.”
Alexander said there are key things to do to prevent more bacteria like CRE from emerging. She said by using antibiotics only when crucial, as well as smaller steps like hand washing, will help prevent the spread of CRE bacteria.
Alexander said local hospitals and the Department of Health are monitoring the situation and working to prevent the spread of infections.